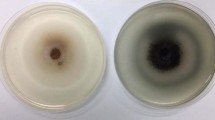

Abstract
The cost-effective production of bioethanol from lignocellulose requires the complete conversion of plant biomass, which contains up to 30 % mannan. To ensure utilisation of galactomannan during consolidated bioprocessing, heterologous production of mannan-degrading enzymes in fungal hosts was explored. The Aspergillus aculeatus endo-β-mannanase (Man1) and Talaromyces emersonii α-galactosidase (Agal) genes were expressed in Saccharomyces cerevisiae Y294, and the Aspergillus niger β-mannosidase (cMndA) and synthetic Cellvibrio mixtus β-mannosidase (Man5A) genes in A. niger. Maximum enzyme activity for Man1 (374 nkat ml−1, pH 5.47), Agal (135 nkat ml−1, pH 2.37), cMndA (12 nkat ml−1, pH 3.40) and Man5A (8 nkat ml−1, pH 3.40) was observed between 60 and 70 °C. Co-expression of the Man1 and Agal genes in S. cerevisiae Y294[Agal-Man1] reduced the extracellular activity relative to individual expression of the respective genes. However, the combined action of crude Man1, Agal and Man5A enzyme preparations significantly decreased the viscosity of galactomannan in locust bean gum, confirming hydrolysis thereof. Furthermore, when complemented with exogenous Man5A, S. cerevisiae Y294[Agal-Man1] produced 56 % of the theoretical ethanol yield, corresponding to a 66 % carbohydrate conversion, on 5 g l−1 mannose and 10 g l−1 locust bean gum.
Similar content being viewed by others
Avoid common mistakes on your manuscript.
Introduction
The abundance and sustainable production of lignocellulosic plant material offers an attractive alternative to the use of fossil fuel reserves for the production of transport fuels [13]. However, the cost-effective production of biofuels from lignocellulosics requires the complete hydrolysis of the plant material, which typically consists of 40–45 % cellulose, 25–50 % hemicellulose and 10–40 % lignin [16]. Mannan and xylan constitute the major hemicellulosic components. Softwoods contain 15–20 % (w/w) mannan with some spruce species containing up to 25 % [19]. Legume seeds can contain more than 30 % mannan per dry weight [6].
Full utilisation of plant biomass requires effective hydrolysis of the different polysaccharides to fermentable sugars. Saccharomyces cerevisiae is effective for bioethanol production from simple sugars, including glucose and mannose [11], but does not produce the enzymes required for galactomannan hydrolysis. If both mannan hydrolysis and fermentation can be performed by a single organism (e.g. a S. cerevisiae strain expressing the required enzymes), it will make a significant contribution to the development of strains for consolidated bioprocessing (CBP) of lignocellulosic plant material. Successful expression of a variety of recombinant cellulases and hemicellulases in S. cerevisiae has demonstrated the potential of CBP for bioethanol production from cellulosic feedstock [27], but effective enzymes for mannan hydrolysis have been elusive.
Mannan is classified as glucomannan, galactomannan and galactoglucomannan depending on its composition. Complete hydrolysis of mannan requires the combined effort of several enzymes, such as β-mannanases (1,4-β-D-mannan mannohydrolases, EC 3.2.1.78), β-mannosidases (1,4-β-D-mannopyranoside hydrolases, EC 3.2.1.25), α-galactosidases (1,6-α-galactoside galactohydrolases, EC 3.2.1.22), β-glucosidases (1,4-β-D-glucoside glucohydrolases, EC 3.2.1.21) and acetyl-mannan esterases (EC 3.1.1.6) [16]. The endo-β-1,4-mannanase cleaves the β-1,4-mannopyranosyl linkages in the mannan backbone, producing oligosaccharides of varying lengths [26]. Hydrolysis of the oligomannans is performed by β-mannosidase, releasing mannose units [16]. In turn, α-galactosidases, β-glucosidases and acetyl-mannan esterases catalyse the removal of galactose, glucose and acetic acid, respectively, from the mannan chain [15, 16].
Enzymes involved in mannan hydrolysis have been identified and characterised in various fungi, in particular in Aspergillus strains [28]. Aspergilli are versatile organisms with the ability to grow on inexpensive substrates, such as agricultural waste [3] and are known for the production of various hydrolytic enzymes. A number of enzymes involved in mannan degradation have been cloned and expressed in foreign hosts [28], with expression of the Aspergillus aculeatus Man1 in Yarrowia lipolytica [21] yielding 26139 nkat ml−1 in fed batch cultivation.
In this study, a recombinant S. cerevisiae strain was constructed to degrade mannan through expression of the A. aculeatus β-mannanase (Man1, GH5) and Talaromyces emersonii α-galactosidase (Agal, GH27). The A. niger and Cellvibrio mixtus β-mannosidases (cMndA (GH2) and Man5A (GH5), respectively) were expressed as functional enzymes in A. niger D15 and evaluated for mannan hydrolysis in combination with Man1 and Agal. The Man5A and Agal exhibit activity on oligo and polymeric substrates, making them the ideal candidates for plant biomass hydrolysis [9, 24]. The enzymes were partially characterised and evaluated on locust bean gum as model substrate. The S. cerevisiae Y294[Agal-Man1] strain demonstrated the conversion of mannan to ethanol under oxygen-limited conditions in the presence of exogenous β-mannosidase. In principle, the use of the recombinant strain could potentially reduce the need for adding external enzymes.
Materials and methods
Media and cultivation
Unless stated otherwise, all chemicals were of analytical grade and were obtained from Merck (Darmstadt, Germany). Escherichia coli DH5α strains were cultured at 37 °C in Terrific Broth (12 g l−1 tryptone, 24 g l−1 yeast extract, 4 ml l−1 glycerol, 0.1 M phosphate buffer) containing 100 µg ml−1 ampicillin [22].
The S. cerevisiae Y294 host strain was maintained on YPD agar plates (10 g l−1 yeast extract, 20 g l−1 peptone and 20 g l−1 glucose) and transformants were selected and maintained on SC−URA agar plates containing 6.7 g l−1 yeast nitrogen base without amino acids [Difco Laboratories], 20 g l−1 glucose and yeast synthetic drop-out medium supplements [Sigma-Aldrich (Germany)]. Aerobic cultivation of S.cerevisiae strains was performed on a rotary shaker (200 rpm) at 30 °C in 125 ml Erlenmeyer flasks containing 25 ml double strength SC−URA medium (2 × SC−URA), 13.4 g l−1 yeast nitrogen base without amino acids [Difco Laboratories], 20 g l−1 glucose and supplemented with yeast synthetic drop-out medium supplements.
The A. niger D15 host strain was maintained on spore plates [18]. For heterologous protein expression, the A. niger fungal strains were cultivated in double strength minimal media (2 × MM, with 100 g l−1glucose, lacking uridine) [20].
Strains and plasmids
The relevant yeast, fungal and bacterial genotypes and plasmids used in this study are listed in Table 1 and the final vector constructs are shown in Fig. 1.
Schematic representation of the final vector constructs expressing a either Aga1 or Man1; b both Aga1 and Man1; and c either Man5A, gMndA or cMndA. d Recombinant S. cerevisiae Y294[Man1] and S. cerevisiae Y294[Agal-Man1] strains displaying extracellular β-mannanase activity on SC−URA agar plates containing 0.5 % (w v) OBR-mannan after 24 h of incubation at 30 °C
DNA manipulations and plasmid construction
Standard protocols were followed for DNA manipulation [22] with enzymes for restriction digests and ligations sourced from Roche applied science (Germany) and used as recommended by the supplier. The Agal (Accession nr EU106878) and Man1 (Accession nr L35487) genes were subcloned from pMA-RQ-Agal (Table 1) and pBluescript-Man1 [23] and cloned onto yBBH1, resulting in yBBH1-Agal and yBBH1-Man1, respectively (Fig. 1a). The ENO1 P -Agal-ENO1 T cassette was excised from yBBH1-Agal with BamHI and BglII and cloned into the BamHI site of yBBH1-Man1, yielding yBBH1-Agal-Man1 (Fig. 1b). The synthetically designed C. mixtus β-mannosidase (Man5A) (Accession nr AY526725) was codon-optimised (GeneArt®) for expression in S. cerevisiae and the truncated Man5A gene (without a secretion signal) was cloned in frame with the XYNSEC coding region onto pGTP2, generating pGTP2-Man5A (Fig. 1c).
The cDNA and genomic copy of the mannosidase gene of A. niger (designated cMndA and gMndA, respectively) were cloned from the A. niger 10864 strain. The strain was grown in minimal media for 72 h, the mycelia harvested and total nucleic acid isolated according to La Grange et al. [14]. Total cDNA was generated using the RevertAid™ H Minus First Strand cDNA Synthesis Kit and OligoT primer (Fermentas) and used for amplification of the 2.8-kb cMndA gene (Accession nr XM_001394595) using the GeneAmp® PCR system 9700 (Applied biosystems), TaKaRa™ Ex Taq™ Polymerase (TaKaRa Bio Inc.) and primers AnmndA-R (5′-TAGGCGCGCCTGCGAATGCTA TTGATAAT-3′) and AnmndA-L (5′-GCTTAATTAACCCTTCTAGCTGTA CGC-3′). The PCR product was digested with PacI and AscI and cloned into the corresponding sites of pGTP2, yielding pGTP2-cMndA (Fig. 1c). Similarly, the gMndA was amplified from the total nucleic acids and cloned onto pGTP2, yielding pGTP2-gMndA.
Bacterial and fungal transformations
Recombinant plasmids were transformed into chemically competent Escherichia coli DH5α cells, followed by selection on LB-Amp agar plates containing 100 µg ml−1 ampicillin [22]. Electro-competent S. cerevisiae Y294 cells [8] were transformed with plasmids yBBH1-Agal, yBBH1-Man1, yBBH1-Agal-Man1 and yBBH1, followed by selection on SC−URA agar plates. Spheroplasts of the A. niger D15 host strain [18] were transformed with plasmids pGTP2-cMndA, pGTP2-Man5A and pGTP2. The A. niger D15 transformants were selection for on minimal medium agar plates lacking uridine. The S. cerevisiae Y294[BBH1] and A. niger D15[GTP2] strains served as reference strains.
Enzyme characterisation
All substrates (except OBR-mannan) and standards for enzyme activity measurements were sourced from Sigma-Aldrich (Germany). The presence of extracellular β-mannanase activity was confirmed on OBR-mannan plates, i.e. SC−URA plates with 0.5 % (w/v) OBR-mannan [5]. The recombinant S. cerevisiae strains were transferred (spotted) onto the OBR-mannan plates and secretion of β-mannanase was indicated by a clear zone around the colony after cultivation at 30 °C for 24 h.
The recombinant S. cerevisiae and A. niger strains were inoculated at a final concentration of 1 × 106 cells/spores ml−1 in 2 × SC−URA and 2 × MM, respectively. Supernatant was harvested at regular intervals and used to determine the extracellular enzyme activity. The β-mannanase activity was determined using the reducing sugar assay [4] using 0.5 % (w/v) locust bean gum as substrate and mannose as standard. The colorimetric changes were measured spectrophotometrically at 540 nm with an X-MARK™ microtitre plate reader (Biorad, Hercules, CA, USA), and β-mannanase activity was expressed in nkat ml−1, where 1 katal equals 1 mol of mannose released per second.
The β-mannosidase and α-galactosidase activities were determined using 2 mM of p-nitrophenyl β-D-mannopyranoside (pNPM) and 2 mM p-nitrophenyl α-galactopyranoside (pNPGal), respectively, as substrates in 50 mM citrate buffer (pH 3.4). The supernatant and substrate (50 µl each) were incubated for 5 min at 50 °C and the reactions terminated by the addition of 200 µl of 1 M sodium carbonate. Colorimetric changes were measured at 400 nm on a microtitre plate reader using p-nitrophenol (pNP) as the standard. Enzyme activities were expressed in nkat ml−1, where 1 katal equals 1 mol of pNP released per second.
The pH and temperature optima of Man1, cMndA, Man5A and Agal in the fungal supernatants were determined (as described above) using their respective substrates in 50 mM citrate phosphate buffer at pH values ranging from 1.72 to 7.20. The temperature optimum was determined by performing the assays at temperatures ranging from 30 to 80 °C.
Locust bean gum rheology
The recombinant Man1, Agal and Man5A enzymes were added at a final concentration of 2 nkat ml−1 to a 0.5 % (w/v) locust bean gum solution prepared in 50 mM citrate buffer at pH 5. Viscosity measurements were performed in triplicate on a Physica MCR 501 (Anton Paar, Germany) using a double-gap configuration and heating at 50 °C with a Peltier system (C-PTD200). Flow curves were analysed using the Rheoplus software based on measurements taken at regular intervals over 10 min at a shear rate of 61.9 s.
Fermentation studies
Pre-cultures of S. cerevisiae Y294[BBH1] and S. cerevisiae Y294[Agal-Man1] were prepared overnight in 2 × SC−URA medium and inoculated at a final concentration of 50 g l−1 in 2 × SC−URA medium containing 5 g l−1 glucose and 10 g l−1 locust bean gum. Ampicillin (100 µg ml−1) and streptomycin (15 µg ml−1) were added to inhibit bacterial contamination. Lyophilised β-mannosidase, Man5A, was added to a final concentration of 300 mg l−1 (7.5 nkat ml−1). Agitation and incubation were done on a magnetic multi-stirrer at 30 °C, with regular sampling with a syringe needle pierced through a rubber stopper.
Ethanol, glycerol, acetic acid, mannose and glucose concentrations were quantified with high-performance liquid chromatography (HPLC) using a surveyor plus liquid chromatograph (Thermo scientific) with a refractive index detector. The compounds were separated on a Rezex RHM Monosaccharide 7.8 × 300 mm column (00H0132-K0, Phenomenex) at 60 °C with 5 mM H2SO4 as mobile phase at a flow rate of 0.6 ml min−1.
Results
Strain construction and functional expression of recombinant genes
The S. cerevisiae Y294 strain was used as host for the heterologous production of the A. aculeatus β-mannanase (Man1) and T. emersonii α-galactosidase (Agal), expressed from the multi-copy, episomal vector yBBH1 under control of the constitutive S. cerevisiae enolase I gene (ENO1) promoter and terminator sequences (Fig. 1a, b). The 1 403-bp synthetic C. mixtus β-mannosidase Man5A gene displayed 100 % homology to the Man5A gene [9]. The A. niger gMndA fragment had a 96.86 % DNA homology with the published gene sequence [1], but contained three introns (237–354; 434–487; and 720–775) as opposed to the two introns reported by Ademark et al. [1]. In addition, a 3-bp deletion was identified at position 197 in cMndA. However, activity was evident on p-nitrophenyl β-D-mannopyranoside (pNPM).
The cMndA (with its native secretion signal sequence) and Man5A (with the XYNSEC secretion signal) were subcloned into the A. niger expression vector, pGTP2, under control of the constitutive A. niger glyceraldehyde-3-phosphate dehydrogenase promoter (gpd P ) and A. awamori glucoamylase terminator (glaA T ) sequences (Fig. 1c). The final plasmid constructs were transformed into S. cerevisiae Y294 (plasmids yBBH1-Agal, yBBH1-Man1, yBBH1-Agal-Man1 and yBBH1) and A. niger D15 (plasmids pGTP2-cMndA, pGTP2-Man5A and pGTP2).
Partial characterisation of recombinant enzymes
A clear zone around S. cerevisiae Y294[Man1] and S. cerevisiae Y294[Agal-Man1] transformants on OBR-mannan plates (Fig. 1d) confirmed endo-mannanase activity. As expected, no zones were observed for S. cerevisiae Y294[BBH1] (reference strain) and S. cerevisiae Y294[Agal], which lacked endo-mannanase genes.
Diluted supernatant containing recombinant MndA and Man5A displayed maximum activity at pH 3.40, whereas Man1 peaked at pH 5.47 and Agal at pH 2.37 when incubated for 30 min at 50 °C (Fig. 2a). Optimal activity for Agal was observed at 60 and at 70 °C for Man5A, MndA and Man1 (Fig. 2b) when incubated for 30 min at their respective optimal pH values.
Using the predetermined optimal conditions for the enzymes, maximum β-mannosidase activity for A. niger D15[cMndA] (11.6 nkat ml−1) was observed after 156 h (Fig. 3a), which was 1.5-fold higher than A. niger D15[Man5A]. The α-galactosidase activity for S. cerevisiae Y294[Agal] reached 131.6 nkat ml−1 after 48 h, i.e. 2.8-fold higher than S. cerevisiae Y294[Agal-Man1] (Fig. 3b). The S. cerevisiae Y294[Man1] strain also produced a 1.2-fold higher endo-mannanase activity (374.17 nkat ml−1) than the co-expressing S. cerevisiae Y294[Agal-Man1] strain (326.67 nkat ml−1) at 36 h (Fig. 3c).
a Extracellular mannosidase activity in (filled square) A. niger D15[cMndA], (filled triangle) A. niger D15[Man5A] and (opened diamond) A. niger D15[GTP2]. b Extracellular galactosidase and c endo-mannanase activity in (opened circle) S. cerevisiae Y294[BBH1], (filled circle) S. cerevisiae Y294[Man1], (filled diamond) S. cerevisiae Y294[Agal] and (opened square) S. cerevisiae Y294[Agal-Man1]. Error bars indicate the standard deviation from the mean value
Mannanases decrease the viscosity of locust bean gum
A gradual decrease in viscosity of galactomannan in 0.5 % locust bean gum was observed for the reference sample due to the influence of temperature and sheering by the apparatus. When the rheology values for the enzyme treatments were normalised accordingly, little change in viscosity occurred in the presence of crude supernatant from S. cerevisiae Y294[Agal] (Fig. 4). Crude extracts containing recombinant mannosidase (Man5A) had a significant influence on the viscosity of the substrate, with an even stronger impact from the mannanase (Man1). The combined crude extracts containing Man1, Agal and Man5A proved to be the most effective for liquefaction of the mannan in locust bean gum, with almost complete liquefaction after 4 min.
Analysis of the hydrolytic effect of the recombinant enzymes on the viscosity of 0.5 % (w/v) locust bean gum. The (filled circle) Agal, (opened square) Man1 and (opened circle) Man5A were evaluated individually and in different combinations: (filled diamond) Agal and Man5A; (opened diamond) Man1 and Man5A; (filled triangle) Man1 and Agal; and (filled square) Man1, Agal and Man5A. Values had been normalised to take into account the effect of the temperature and shearing on the viscosity. Error bars indicate the standard deviation from the mean value
The S. cerevisiae Y294[BBH] and S. cerevisiae Y294[Agal-Man1] strains were monitored for ethanol production under oxygen-limited conditions using mannose and locust bean gum as carbohydrate source. After 6 days of fermentations, the mannose production and utilisation reached equilibrium (Fig 5). After 12 days of fermentation in SC−URA medium, the S. cerevisiae Y294[BBH] and S. cerevisiae Y294[Agal-Man1] strains produced a maximum of 0.103 and 4.56 g l−1 ethanol, respectively (Fig. 5). Given the presence of 5 g l−1 mannose and 10 g l−1 locust bean gum in the growth medium, this implies that S. cerevisiae Y294[Agal-Man1] produced 56 % of the theoretical ethanol yield and obtained a 66 % conversion of the available carbohydrate to ethanol (Table 2).
The a mannose consumption and b ethanol production by (filled diamond) S. cerevisiae Y294[BBH1] and (filled square) S. cerevisiae Y294[Agal-Man1] were monitored under oxygen-limited conditions in double strength SC−URA media (10 g l−1 locust bean gum and 5 g l−1 mannose). The cultures had been supplemented with 100 mg of lyophilised Man5A at time 0. Values represent the mean of three repeats and error bars represent the standard deviation
Discussion
Since cellulose and starch are by far the most abundant polysaccharides in nature, research on bioethanol production from plant biomass has concentrated on the utilisation of these two substrates. However, mannan can constitute up to 30 % of the plant biomass [6] and can thus not be ignored if the ethanol yield derived from plant biomass needs to be maximised. However, hydrolysis of mannan requires the action of a number of enzymes, including β-mannanases, β-mannosidases, α-galactosidases, β-glucosidases and acetyl-mannan esterases, which are not part of the native S. cerevisiae secretome.
To construct yeast strains capable of degrading and/or utilising mannan, a number of fungal enzymes were targeted for heterologous expression. The A. aculeatus Man1 gene was previously expressed in S. cerevisiae using the PGK1 promoter and terminator expression cassette [23], whilst the T. emersonii Agal gene was expressed in Pichia pastoris [24]. In the present study, the Man1 and Agal genes were subcloned onto the yBBH1 vector and expressed in S. cerevisiae. The A. niger MndA [1, 2, 10] and C. mixtus Man5A [7, 9] β-mannosidase enzymes have previously been characterised and Man5A expressed in E. coli [7, 9]. The strategy requires the addition of the mannosidase externally. Therefore, the cMndA and Man5A had been expressed using an A. niger strain known for its high levels of expression [20, 21].
Both MndA and Man5A displayed optimum activity at pH 3.4 and 70 °C (Fig. 2). The results for MndA fall within the range previously reported [2], but the optimum pH for Man5A falls well below the optimal pH 7.0 reported by Dias et al. [9]. The Man1 and Agal displayed optimum activity at 70 °C and pH 5.47, and 80 °C and pH 2.37, respectively (Fig. 2). Setati et al. [23] reported 50 °C and pH 3 as optima for the Man1 expressed in S. cerevisiae, whereas Similä et al. [24] reported 70 °C and pH 4.5 as optimal for Agal expression in P. pastoris. The deviation in optimal conditions may be ascribed to the different host strains and media composition, which could impact glycosylation patterns and thus the characteristics of the enzymes [25].
All the recombinant enzymes were partially characterised in terms of enzyme activity, pH and temperature preferences as well as their effect on the viscosity of galactomannans (locust bean gum). The A. niger D15[cMndA] strain produced more β-mannosidase activity than A. niger D15[Man5A] (Fig. 3a), but these values are significantly lower than those previously reported [1, 2]. This may be due to the high copy numbers (up to 25) of the vectors used by Ademark et al. [1] and the absence of 3 bp in the cDNA copy of MndA in the present study, which may have led to sub-optimal protein folding or functionality.
The extracellular α-galactosidase and β-mannanase activities from S. cerevisiae Y294[Agal], S. cerevisiae Y294[Man1] and S. cerevisiae Y294[Agal-Man1] on locust bean gum were higher than those that were co-expressed (Fig. 3b, c). The maximum α-galactosidase activity from S. cerevisiae Y294[Agal] was 2.3-fold higher than from S. cerevisiae Y294[Agal-Man1], whilst the maximum β-mannanase activity from S. cerevisiae Y294[Man1] was 1.1-fold higher than from S. cerevisiae Y294[Agal-Man1]. The yBBH1-Agal-Man1 plasmid is significantly larger than yBBH1-Agal and yBBH1-Man1, which could result in a lower copy numbers and thus lower protein levels. The maximum Agal activity observed in this study (135 nkat ml−1) was slightly more than the 116 nkat ml−1 reported for its expression in P. pastoris [24].
The recombinant Man1 and Man5A significantly reduced the viscosity of locust bean gum, whereas Agal1 had no impact on galactomannan (Fig. 4). Since no endo-mannanase activity was detected in the Man5A crude extract (in agreement with [9]), the reduced viscosity was probably due to the release of mannose from the non-reducing end of the mannan chain, resulting in a gradual decrease in molecular weight. The addition of Agal to either Man1 or Man5A further reduced the viscosity of the locust bean gum, which was attributed to the removal of galactose side chains by Agal and thus exposed more possible sites of attack for Man1 and Man5A. The combination of Man1 and Man5A amplified the decrease in viscosity, probably due to the production of shorter oligosaccharides. However, a combination of all three enzymes (Man1, Agal and Man5A) did not significantly reduced viscosity more than that observed for the two-way combinations. It is plausible that the increased mannose and galactose levels could have resulted in feedback inhibition of the enzymes.
When Man5A was added, S. cerevisiae Y294[Agal-Man1] produced 5-fold more ethanol than the control strain on 5 g l−1 mannose and 10 g l−1 locust bean gum (Fig. 5). The 66 % carbohydrate conversion was lower than expected, but could be ascribed to possible exhaustion of the β-mannosidase Man5A enzyme, which was added once-off at the beginning of the fermentation. Little mannose was detected throughout the fermentation, indicating that the mannose was consumed immediately upon release. The mannose production and consumption reached equilibrium at day 6.
To our knowledge, this is the first report on ethanol production by S. cerevisiae using mannan as a carbohydrate source. The T. emersonii α-galactosidase was successfully expressed by itself and in combination with a mannanase in S. cerevisiae. The A. niger strain provided an effective alternative expression system for cMndA and Man5A, representing the first report on Man5A expression in A. niger. The combination of β-mannanase and either β-mannosidase or α-galactosidase indicated a significant reduction in the viscosity of galactomannan when compared with the individual enzymes.
For consolidated bioprocessing of mannan, the ideal scenario would be to express a mannanase, α-galactosidase and β-mannosidase (and β-glucosidase for galactogluco mannan or glucomannan) in a single host (e.g. S. cerevisiae) for continuous enzyme production, thus allowing complete hydrolysis of mannan and simultaneous fermentation of the sugar components. However, this would require the expression of a functional β-mannosidase in S. cerevisiae, which has been unsuccessful to date.
References
Ademark P, De Vries RP, Hägglund P, Stålbrand H, Visser J (2001) Cloning and characterization of Aspergillus niger genes encoding an α-galactosidase and a β-mannosidase involved in galactomannan degradation. Eur J Biochem 268:2982–2990
Ademark P, Lundqvist J, Hägglund P, Tenkanen M, Torto N, Tjerneld F, Stålbrand H (1999) Hydrolytic properties of a β-mannosidase purified from Aspergillus niger. J Biotechnol 75:281–289
Aristidou A, Penttilä M (2000) Metabolic engineering applications to renewable resource utilization. Curr Opin Biotechnol 11:187–198
Bailey MJ, Biely P, Poutanen K (1992) Interlaboratory testing of methods for assay of xylanase activity. J Biotechnol 23:257–270
Biely P, Mislovičová D, Toman R (1985) Soluble chromogenic substrates for the assay of endo-1,4-β-xylanases and endo-1,4-β-glucanases. Anal Biochem 144:142–146
Buckeridge MS (2010) Seed cell wall storage polysaccharides: models to understand cell wall biosynthesis and degradation. Plant Physiol 154:1017–1023
Centeno MSJ, Guerreiro CIPD, Dias FMV, Morland C, Tailford LE, Goyal A, Prates JAM, Ferreira LMA, Caldeira RMH, Mongodin EF, Nelson KE, Gilbert HJ, Fontes CMGA (2006) Galactomannan hydrolysis and mannose metabolism in Cellvibrio mixtus. FEMS Microbiol Lett 261:123–132
Cho KM, Yoo YJ, Kang HS (1999) δ-Integration of endo exo-glucanase and β-glucosidase genes into the yeast chromosomes for direct conversion of cellulose to ethanol. Enzyme Microb Technol 25:23–30
Dias FMV, Vincent F, Pell G, Prates JAM, Centeno MSJ, Tailford LE, Ferreira LMA, Fontes CMGA, Davies GJ, Gilbert HJ (2004) Insights into the molecular determinants of substrate specificity in glycoside hydrolase family 5 revealed by the crystal structure and kinetics of Cellvibrio mixtus mannosidase 5A. J Biol Chem 279:25517–25526
Do BC, Dang TT, Berrin JG, Haltrich D, To KA, Sigoillot JC, Yamabhai M (2009) Cloning, expression in Pichia pastoris, and characterization of a thermostable GH5 mannan endo–1,4–beta-mannosidase from Aspergillus niger BK01. Microb Cell Fact 8:59
Gírio FM, Fonseca C, Carvalheiro F, Duarte LC, Marques S, Bogel-Łukasik R (2010) Hemicelluloses for fuel ethanol: a review. Bioresour Technol 101:4775–4800
Gordon CL, Khalaj V, Ram AFJ, Archer DB, Brookman JL, Trinci APJ, Jeenes DJ, Doonan JH, Wells B, Punt PJ, van den Hondel CAMJJ, Robson GD (2000) Glucoamylase:green fluorescent protein fusion to monitor protein secretion in Aspergillus niger. Microbiol 146:415–426
Hamelinck CN, van Hooijdonk G, Faaij APC (2005) Ethanol from lignocellulosic biomass: techno-economic performance in short-, middle-, and long-term. Biomass Bioenerg 28:384–410
La Grange DC, Pretorius IS, Van Zyl WH (1996) Expression of a Trichoderma reesei β-xylanase gene (XYN2) in Saccharomyces cerevisiae. Appl Environ Microbiol 62:1036–1044
McCutchen CM, Duffaud GD, Leduc P, Petersen ARH, Tayal A, Khan SA, Kelly RM (1996) Characterization of extremely thermostable enzymatic breakers (α-1,6-galactosidase and β-1,4-mannanase) from the hyperthermophilic bacterium Thermotoga neapolitana 5068 for hydrolysis of guar gum. Biotechnol Bioeng 52:332–339
Moreira LRS, Filho EXF (2008) An overview of mannan structure and mannan-degrading enzyme systems. Appl Microbiol Biotechnol 79:165–178
Njokweni AP, Rose SH, Van Zyl WH (2012) Fungal β-glucosidase expression in Saccharomyces cerevisiae. J Ind Microbiol Biotechnol 39:1445–1452
Punt PJ, Van den Hondel CAMJJ (1992) Transformation of filamentous fungi based on hygromycin B and phleomycin resistance markers. Methods Enzymol 216:447–457
Rodríguez-Gacio MC, Iglesias-Fernández R, Carbonero P, Matilla AJ (2012) Softening-up mannan-rich cell walls. J Exp Bot 63:3976–3988
Rose SH, Van Zyl WH (2002) Constitutive expression of the Trichoderma reesei β-1,4–xylanase gene (xyn2) and the β-1,4-endoglucanase gene (egI) in Aspergillus niger in molasses and defined glucose media. Appl Microbiol Biotechnol 58:461–468
Roth R, Moodley V, van Zyl P (2009) Heterologous expression and optimized production of an Aspergillus aculeatus endo-1,4-β-mannanase in Yarrowia lipolytica. Mol Biotechnol 43:112–120
Sambrook J, Fritsch EF, Miniatis T (1989) Molecular cloning: a laboratory manual. Cold Spring Harbor Laboratory Press, Cold Spring Harbor
Setati ME, Ademark P, Van Zyl WH, Hahn-Hägerdal B, Stålbrand H (2001) Expression of the Aspergillus aculeatus endo-β-1,4-mannanase encoding gene (Man1) in Saccharomyces cerevisiae and characterization of the recombinant enzyme. Protein Expr Purif 21:105–114
Similä J, Gernig A, Murray P, Fernandes S, Tuohy MG (2010) Cloning and expression of a thermostable α-galactosidase from the thermophilic fungus T. emersonii in the methylotrophic yeast Pichia pastoris. J Microbiol Biotechnol 20:1653–1663
Stals I, Sandra K, Geysens S, Contreras R, Van Beeumen J, Claeyssens M (2004) Factors influencing glycosylation of Trichoderma reesei cellulases. I: post secretorial changes of the O- and N-glycosylation pattern of Cel7A. Glycobiology 14:713–724
Stoll D, Boraston A, Stålbrand H, McLean BW, Kilburn DG, Warren RAJ (2000) Mannanase Man26A from Cellulomonas fimi has a mannan-binding module. FEMS Microbiol Lett 183:265–269
Van Zyl WH, Lynd LR, den Haan R, McBride ME (2007) Consolidated bioprocessing for bioethanol production using Saccharomyces cerevisiae. Adv Biochem Eng Biotechnol 108:205–235
Van Zyl WH, Rose SH, Trollope K, Görgens JF (2010) Fungal β-mannanases: mannan hydrolysis, heterologous production and biotechnological applications. Process Biochem 45:1203–1213
Acknowledgments
The authors would like to express their sincere gratitude to the South African National Energy Research Institute (SANERI), the Department of Science and Technology (DST) and the National Research Foundation of South Africa (numbers 61,170, 76,597 to MVB and 68,955 to WHvZ) for financial support.
Author information
Authors and Affiliations
Corresponding author
Rights and permissions
About this article
Cite this article
Malherbe, A.R., Rose, S.H., Viljoen-Bloom, M. et al. Expression and evaluation of enzymes required for the hydrolysis of galactomannan. J Ind Microbiol Biotechnol 41, 1201–1209 (2014). https://doi.org/10.1007/s10295-014-1459-7
Received:
Accepted:
Published:
Issue Date:
DOI: https://doi.org/10.1007/s10295-014-1459-7